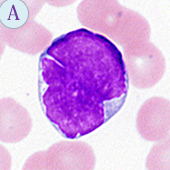

第89回 「マンスリー形態マガジン」 2018年9月号
『日本列島は異変、そこにヒーローがいた』
この夏、日本列島は猛暑から酷暑の日々、裏山のある高台に住むわが家にもセミの鳴き声がうるさく響きます。その一瞬“ホーホケキョ!”エッ、ウグイス?、そういえばウグイスは年に2回繁殖するそうで、遅いものは8月のお盆頃までさえずるらしいです(なっとく‥)。
今年も6月28日~7月8日頃にかけ、西日本を中心に北海道や中部地方、四国地方など全国規模にまたがった豪雨は各地に被害をもたらしました。7月21日警察庁のまとめでは、死者220人、行方不明10人、避難生活4,481人となっています。
西日本豪雨で甚大な浸水被害を受けた岡山県倉敷市真備町で、多くの住民が取り残されるなか、15時間かけて約120人を水上バイクで救助した青年(N氏.29歳)がいました。趣味で水上バイクの免許を取得したNさんは、燃料を何度も補充しながら午前4時頃までに必死に救助を続けました。援助の途中お年寄りに向って“じいちゃん、命がけで助けたんじゃけ、長生きしてよ。絶対で‥”、それに対し、“あんたは、町のヒーロー。命の恩人じゃ”とお返ししたそうです(朝日新聞.2018.7.19)。空からの救済風景はよく見かけますが、陸の救援手段の1つとして国土交通省の危機管理部に更なる検討を託したい。しかし、豪雨の際「宴会自慢」をやらかす想像力欠如の連中にその危機管理能力があるのかは疑問です(恥ずかしい‥)。
“暑中お見舞い申し上げます”この時候の挨拶も、今年の暑さは格別で埼玉・熊谷で観測史上最高41.1度(2018.7.23.14:45)を記録しました。天気予報では“命に関わる危険な暑さ”と報じられ、熱中症対策はもとより“水中毒”にも注意喚起がなされ、水の大量摂取による塩分不足には気をつけたいものです。
熱中症といえば、11年前にさかのぼりますが、第23回那覇フルマラソン(2007.12月)に参加した際、ゴール付近で気分が悪く、吐き気を催し、口の中は砂漠状態、水分補給するも間に合わず、自力で回復したことが想い出されます。12月初めの那覇は気温が高く26度位あり、給水場所では補給するという教訓でした。結局、那覇マラソンは4回完走しておりますが、暑さに勝てずいつも5時間を超えるタイムです。ちなみに最高タイムは、宮崎青島太平洋マラソンで4時間40分でした。
日本列島は今後“酷暑”が予測されますが、感覚障害の高齢者へ向かう私にとってせめて家のなかでの熱中症と水中毒には気をつけたいものです。
形態マガジン号キャプテン 阿南 建一 
今回のねらい
今回は、骨髄におけるリンパ系腫瘍疾患を提示しました。
なかには、特徴ある形態を呈する細胞や鑑別細胞として認識しておかないといけない細胞も含まれています。
症例編は、わずかな臨床像と検査データから次なる検査を模索し、末梢血および骨髄像から臨床診断を試みて下さい。
問題
骨髄の細胞同定を行ってください。
光顕的所見から臨床診断を考えて下さい。
【所見】
【Case7】 35-40歳.男性
主訴:白血球数増加、肝脾腫
WBC120,800/μL、RBC487万/μL、Hb14.3g//dL、Ht44.7%、PLT45.9万/μL、NCC62.4万/μL
-
PB-MG×1000

-
BM-MG×400

-
BM-MG×1000

-
BM-MG×600

解答・解説
問題 1
骨髄像からリンパ性腫瘍疾患を考えてみて下さい。
【解説】

-
今回は、骨髄のリンパ系腫瘍疾患を提示しました。通常、一個よりも周囲の細胞分布様式(多様性か単一)を評価した後、形態診断に及びます。すなわち、単一様式は多くが腫瘍性のポイントになります。
【正答】
A-⑤マントル細胞リンパ腫 B-③成人T細胞白血病 C-⑥リンパ形質細胞リンパ腫 D-①急性リンパ性白血病 E-②バーキットリンパ腫 F-④前リンパ球性白血病
【解説】
A.N/C比は高く、核網工がやや粗剛、10時方向に切れ込みのある核不整がみられ、細胞質には淡い好塩基性が みられたマントル細胞リンパ腫の細胞です。濾胞性リンパ腫の細胞に類似しますが、それは小型で核はほぼ円形で核中心に幅の狭い深い切れ込みが特徴的です。本細胞はB細胞性で、CD5、cyclinD1の発現、11;14転座とCYCLIND1/IgHを認めました。
B.中型の細胞は、核が円形で不整は不明瞭、好塩基性の細胞質内に顕著な空胞がみられます。周囲には不整核を有する細胞もあり、ATL細胞で空胞を有したものです。CD4、CD25の発現と抗HTLV-Ⅰ抗体が陽性でした。
C.類円形の核には3時方向に僅かに切れ込みがみられ、核はやや偏在傾向にあり核網工は粗剛のようです。周囲 にはもう少し小型で核が偏在したものがみられたリンパ形質細胞性リンパ腫の細胞です。IgM-M蛋白が3g/dL以上で、高粘稠度症候群を来たしていました。
D.小型~中型の細胞で、細胞の集合性から骨髄での増加が予想され、急性白血病が考えられます。本細胞には空胞がみられますが、本診断の決め手にはなりません。PO染色に陰性とTdT、CD19、cyCD79a、HLA-DRが陽性から、前駆Bリンパ芽球性白血病と診断されました。
E.大型で、N/C比はやや高く、核網工は粗剛で、核小体はやや不明瞭です。好塩基性の細胞質には空胞が散見されます。その好塩基性は辺縁部に強度で深みさえ感じます。バーキットリンパ腫の細胞で、8;14転座とc-myc/IgHが証明されました。
F.中型の大きさで、N/C比は高く、円形核には明瞭な核小体がみられます。弱い好塩基性の細胞質には突起がみられます。核小体が特徴で周囲には不整核もあり、前リンパ球性白血病の細胞です。成熟B細胞性で、FMC7やIgM+Dが強く発現していました。臨床的には孤立性脾腫が特徴とされます。
問題 2
35-40歳.男性。白血球数の著増と肝脾腫がみられました。
【解説】
(PB-MG×1000)

(BM-MG×400)

(BM-MG×1000)

(BM-MG×600)

-
【末梢血】
(A)白血球数著増(120,800/µL)の白血球分類では、左方移動に伴い幼若顆粒球の増加と好塩基球の増加(9,664/µL)が特徴でした。NAP染色で好中球のNAP活性が低値でした。
【骨髄】
(B)過形成(62.4万/µL)の骨髄像の分類では、芽球の増加を認めない顆粒球系の分化過程が優位で、赤芽球系の抑制がみられました。好塩基球は4%で、巨核球の増加もみられ、大半が成熟過程にあるものでしたが、一部に低分葉核巨核球がみられました。
【染色体/遺伝子】
9;22転座の核型異常、BCR-ABL1遺伝子を認めました。
【臨床診断】
末梢血では白血球数の著増がみられ、左方移動は幼若顆粒球の増加を伴っていたことから病的左方移動*と思われます。骨髄の過形成は芽球の増加を認めない顆粒球系の分化過程の増加であり、特に末梢血の好塩基球の増加や好中球のNAP活性が低値であったことから慢性骨髄性白血病(CML)の慢性期が疑われました。染色体検査で、9;22転座とBCR-ABL1遺伝子変異を認めたことからCMLと診断され、臨床病期はCMLの慢性期として診断されました。
*私見ですが、左方移動についてふれます。左方移動は、一般に桿状核球の増加と幼若顆粒球の出現を伴った状態とされます。そのなかで、骨髄球あたりまでの出現の場合は感染症などに多く、骨髄芽球や前骨髄球が絡んでくると慢性骨髄性白血病(CML)などで遭遇するようです。両者には若干出現様式が異なるため、前者を反応性左方移動、後者を病的左方移動として捉えるようにしています。
これから先のページでは、医療関係者の方々を対象に医療機器・体外診断薬等の製品に関する情報を提供しております。当社製品を適正に使用していただくことを目的としており、一部の情報では専門的な用語を使用しております。
一般の方への情報提供を目的としたものではありませんので、ご了承ください。
医療関係者の方は、次のページへお進みください。
(お手数ですが、「進む」ボタンのクリックをお願いします)






